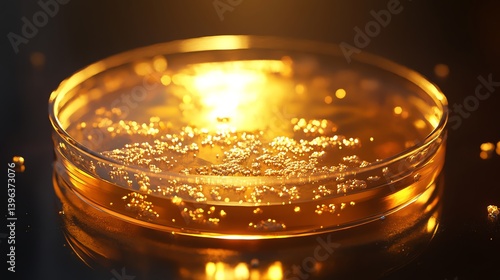

Download Muster
Download Muster
Datei Details
Veröffentlicht: 2025-04-10 03:19:41.388157
Kategorie: Drinks
Typ: Foto
Model release: NEIN
Share
Petri Dish Close-up with Liquid and Particles for Scientific Analysis
Schlüsselwörter
liquid,
particle,
solution,
culture,
experiment,
laboratory,
research,
analysis,
science,
scientific,
closeup,
transparent,
plate,
dish,
sample,
fluid,
gold,
glistering,
round,
container,
glasses,
shiny,
illuminated,
black background,
organism,
growth,
studying,
medicals,
medicine,
biology,
chemical,
health care,
pharmaceutical,
testing